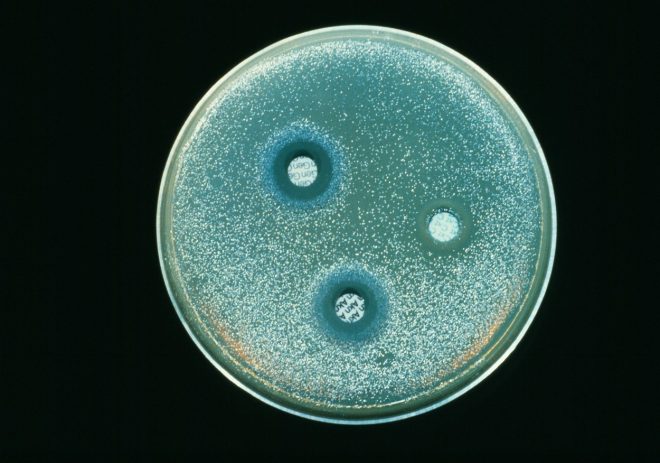

Mila in razkužila za roke, ki vsebujejo sredstva za dezinfekcijo na osnovi izopropanola ali etilnega alkohola, se uporablja po vsem svetu in so pomembno prispevala k zmanjšanju pojavnosti superbakterije, imenovane proti meticilinu odporni Staphylococcus aureus oz. mrsa.
Bakterije so izjemno prilagodljive
A raziskovalci so sedaj opazili porast druge vrste bakterije, ki se nahaja v črevesju, in sicer enterokoka Enterococcus faecium. Ta se lahko v bolnišničnem okolju širi prek katetrov ali respiratorjev.
“Na zdravila odporne okužbe z E. faecium so porasle kljub uporabil alkoholnih razkužil in trenutno predstavljajo največji vzrok bolnišničnih okužb,” navaja študija, objavljena v publikaciji Science Translational Medicine.
Enterokoki so na svetovni ravni odgovorni za okoli desetino primerov bolnišničnih bakterijskih okužb in so četrti oz. peti glavni vzrok sepse v Severni Ameriki oz. Evropi.
Odporne na razkužila in antibiotike
V Avstraliji po ocenah tretjino enterokoknih okužb zakrivi prav E. faecium. Pri tem je 90 odstotkov celokupnih okužb z enterokoki odpornih na antibiotik ampicilin, 50 odstotkov pa tudi na vankomicin.
Da bi lahko bolje razumeli razloge za širjenje E. faecium, so avstralski raziskovalci analizirali vzorce bakterij iz dveh bolnišnic v Melbournu, zajetih med letoma 1997 in 2015. In ugotovili so, da so vzorci bakterij, zbrani po letu 2009, v povprečju bolj odporni na alkohol kot tisti, zbrani pred letom 2004.
Odpornost v tem primeru pomeni, da lahko bakterija dlje preživi izpostavljenost alkoholu in se tako lahko izogne smrti ter posledično povzroči okužbo, je navedel avtor študije Time Stinear, mikrobiolog z inštituta Doherty za imunost in infekcije na melbournski univerzi.
Je pa hkrati miril, da so raziskovane bakterije še daleč od tega, da bi postale povsem odporne na alkohol. Potrebne so nadaljnje študije, s katerimi bi ugotovili, da je E. faecium vse bolj odporna na razkužila tudi v drugih bolnišnicah po svetu.
acebook spreminja nastavitve, zato boste v prihodnje lahko videvali manj vsebin, ki jih z vami delimo na naših straneh. Če želite, da objavo, ki se vam zdi zanimiva, vidijo tudi vaši prijatelji, jo delite naprej